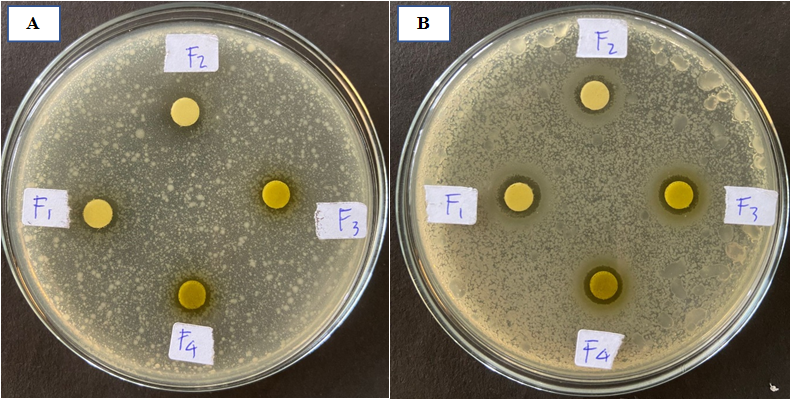

1Faculty of Pharmacy, Universitas Sumatera Utara, Medan, Indonesia, 20155. 2Nanomedicine Center of Excellence Innovation, Universitas Sumatera Utara, Medan, Indonesia, 20155. 3Department of Chemistry, Faculty of Pharmacy, Universitas Sumatera Utara, Medan, Indonesia, 20155
Email: lialaila@usu.ac.id
Received: 21 Dec 2022, Revised and Accepted: 28 Feb 2023
ABSTRACT
Objective: This study aimed to develop a topical nanoemulsion using clove oil and ethanol extract of catharanthus roseus (L.) G. for antioxidant and antibacterial dosage form.
Methods: The nanoemulsion was produced using a spontaneous emulsification method. The formulation was carried out using tween 80 and pluronic 127 as surfactants with different extract concentrations (0.5–2%). The characterizations of the formula included organoleptic test, homogeneity, pH determination, emulsion type, viscosity, particle size determination, zeta potential, and stability test were evaluated. Antioxidant activity was conducted using DPPH method and antibacterial activity was determined against propionibacterium acnes and Staphylococcus epidermidis.
Results: The result showed that all the formulations produced a stable nanoemulsion with semisolid, clarity, transparent and homogenous characteristic. The nanoemulsion had pH of 5.5-6.5 and belong to oil in water (O/W) type of emulsion. The formula showed viscosity ranged from 121.33±0.29 until 211.01±1.00 cps, had particle size below than 300 nm, and were stable for 3 mo of storage and after accelerated evaluation. nanoemulsion contained 2% of c. roseus extract showed moderate antioxidant activity with IC50 value of 96.29±3.64 and antibacterial activity with 10.65±0.15 and 13.27±0.21 mm of inhibition zones for propionibacterium acnes and Staphylococcus epidermidis, respectively.
Conclusion: Clove oil combined with the ethanol extract of c. roseus produced a stable nanoemulsion, which demonstrated concentration-dependent antioxidant and antibacterial activities.
Keywords: Clove oil, Catharanthus roseus (L.) G. Don., Nanoemulsion, Stability, Antioxidant, Antibacterial
© 2023 The Authors. Published by Innovare Academic Sciences Pvt Ltd. This is an open access article under the CC BY license (https://creativecommons.org/licenses/by/4.0/)
DOI: https://dx.doi.org/10.22159/ijap.2023v15i3.47138. Journal homepage: https://innovareacademics.in/journals/index.php/ijap
Clove oil is one of the essential oils that often used by local communities for medicinal purposes [1]. It also contains several ingredients with different pharmacological effects, such an antibacterial, antiinflammation, analgesic, and antioxidant [2-7]. The development of clove oil in various pharmaceutical dosage forms has been carried out to improve comfort during use. Clove oil had been proven as oil phase in the antibacterial nanoemulsion using tween 80 and Span 80 as emulsifier prepared by Shahavi, et al. using ultrasonication method and also by Shun, et al. with the same emulsifier but using the spontaneous emulsification method [8, 9].
Nanoemulsion is an emulsion system that is transparent or translucent. It is also an oil-water dispersion stabilized by a film layer of surfactant or molecules, which have droplets in nano size [10]. The small size makes the nanoemulsion kinetically stable, thereby preventing coalescence and creaming during storage [11]. Furthermore, it is often used in the food industry [12], drug delivery systems [13-15], cosmeceutical [16], and others industries. Nanoemulsion have several advantages, such as the ability to increase the rate of absorption and bioavailability of poorly soluble drug [17, 18] as well as increase the dosage form stability [19]. Some vegetable oils have been developed into nanoemulsion for various drugs, such as castor oil for natrium diclofenac [20], palm oil for propofol injection [21], and pomegranate seed oil for ketoprofen [22].
Catharanthus roseus (L.) G. (C. roseus) is a plant with several medicinal benefits, such as antidiabetic, antioxidant, [23, 24], antibacterial, [25], antidiarrheal [26], and antihyperglycemic activities [27]. C. roseus contains significant quantities of volatile and phenolic compounds including caffeoylquinic acids and flavonol glycosides which are known to retain antioxidant activity. Leaves extract from this plant also know to have a good efficacy against microorganism thus it could be used as precautionary agent in the treatment of numerous of the illness [28]. This potentiality can be utilized to create a dosage form that possesses antioxidant and antibacterial activity for topical usage purposes, such as anti-aging and anti-acne dosage form.
Therefore, this study aimed to develop a nanoemulsion formulation loaded with c. roseus extract using clove oil as the oil phase which demonstrated the antioxidant and antibacterial activity. The addition of c. roseus extract in clove oil based nanoemulsion was expected to improve the pharmacological effect of the dosage form. Evaluation of physical characterization and stability test for nanoemulsion produced were also carried out to evaluate the quality of the nanoemulsion.
Materials
Pluronic 127 and 96% ethanol were purchased from Sigma Aldrich (Singapore) and from Merck, respectively. The clove oil, tween 80, poly ethylene glycol (PEG) 400, methyl paraben, propyl paraben, and distilled water were obtained from Smart Chemical Lab, Jakarta, Indonesia. All the chemicals used in this study were analytical grade.
Plant determination
The plant sample was determined by herbarium medanense, department of biology, faculty of mathematics and natural sciences, Universitas Sumatera Utara, Indonesia with the identification number: 2112/MEDA/2018.
Catharanthus roseus extract (CRE) preparation
Maceration process was selected as the method for the extract preparation. Furthermore, a total of 400 g of c. roseus powder was extracted with 4 liters of 96% ethanol for 7 d based on Indonesian Pharmacopeia method. It was then concentrated using rotary evaporator to produce a crude extract.
Nanoemulsion preparation
The composition of CRE nanoemulsion formula is presented in table 1. The nanoemulsion was produced using a spontaneous emulsification method. The water phase included extract, pluronic 127, and PEG 400 were mixed on a hot plate stirrer at 1,000 rpm at 70 °C for 10 min until a homogenous mixture was obtained. Then, it was mixed with clove oil gently at 70 °C and 1.200 rpm for 5 h. Subsequently, the nanoemulsion was placed in an appropriate package for further evaluation.
Table 1: The composition of the CRE nanoemulsions
| Materials | Formula (%) | |||||
| F0 | F1 | F2 | F3 | F4 | ||
| CRE | - | 0.5 | 1 | 1.5 | 2 | |
| Oil phase | Clove oil | 10 | 10 | 10 | 10 | 10 |
| Surfactants | Tween 80 | 35 | 35 | 35 | 35 | 35 |
| Pluronic 127 | 10 | 10 | 10 | 10 | 10 | |
| Co-surfactant | PEG 400 | 15 | 15 | 15 | 15 | 15 |
| Ethanol | 2.5 | 2.5 | 2.5 | 2.5 | 2.5 | |
| Preservative | Methyl paraben | 0.1 | 0.1 | 0.1 | 0.1 | 0.1 |
| Propyl paraben | 0.01 | 0.01 | 0.01 | 0.01 | 0.01 | |
| Distilled water | Ad 100 | Ad 100 | Ad 100 | Ad 100 | Ad 100 | |
Characterization of nanoemulsion
Physical evaluation
The physical characterization was carried out using organoleptic testing of texture, color, clarity, and separation of the nanoemulsion phase by visual observation. Furthermore, the type of emulsion was determined with methylene blue. Homogeneity test was carried out to assess the quality of the nanoemulsion.
pH determination
pH determination was assayed using a pH meter (Hanna Instrument, Singapore). The electrode was washed with distilled water before and after measurement. Furthermore, the pH was measured using the standard calibration procedure and the electrode was dipped into the nanoemulsion in triplicate. The electrode was rinsed after every measurement to avoid contamination from other sample.
Viscosity measurement
The viscosity of the nanoemulsion was measured using a Viscometer NJ8S with spindle no. 2 at 10–60 rpm, and the test was carried out in triplicate for every sample.
Particle size and zeta potential characterization
The distribution of the particle size and zeta potential value of the nanoemulsion were evaluated using the particle size analyzer nanowave II (Microtrac, USA). Nanoemulsion was put in the cuvette and particle size distribution will be measured by the instrument. The zeta potential was measured by filling the nanoemulsion samples into disposable zeta cell cuvettes and placing them in the sample chamber. The polydispersity index (PDI) was also evaluated for all formula.
Storage stability test
The storage stability test was conducted by evaluating organoleptic, pH and viscosity of the nanoemulsion kept in room storage temperature (25±2 °C) for 3 mo. A good nanoemulsion will be stable and does not change after this test.
Heating-cooling cycle test
The test was adopted from Suciati [29] with some modifications. Nanoemulsion stability was predicted using the heating-cooling cycle for 6 cycles with refrigerator and incubator temperatures of 8±2 °C and 40±2 °C for 12 h, respectively. The organoleptic, pH and viscosity of the nanoemulsion were then evaluated.
Centrifugation test
This test was carried out using a centrifuge (Dynamica,) at 3,800 rpm under room temperature. The nanoemulsion was placed in a tube and centrifuged for 5 h [30]. The nanoemulsion was then evaluated for changes in consistency, pH, and viscosity after the test.
Antioxidant activity
The antioxidant activity of each formula was evaluated using the DPPH method. Subsequently, nanoemulsion with concentrations of 20, 40, 60, 80 and 100 mcg/ml were prepared. The samples were then kept in dark place for 60 min at room temperature. The measurement was carried out using spectroscopy UV-Vis (Shimadzu UV 1800) at wavelength of 516 nm. The result was then compared with ascorbic acid as the positive control. The IC50 value was used as an indicator for antioxidant activity based on previous study [31, 32].
Antibacterial activity against propionibacterium acnes (P. acnes) and staphylococcus epidermidis (S. epidermidis)
The antibacterial activity was tested using the disc diffusion method with different concentrations [33]. Petri dishes were sterilized using oven at 170 °C, while the media was sterilized with autoclave at
121 °C for 15 min. The bacterial suspension isolates were subcultured into the media and standardized with 0.5 McFarland. An aliquot of 0.1 ml of each suspension was pipetted and then placed in petri dish, followed by incubation at 37 °C for 1 x 24 h. The zones of inhibition for all the formula were then measured. Furthermore, the measurement was carried out in triplicate for each sample.
Data analysis
Data were presented as average value and standard deviation (SD). The data analysis in this study used statistical analysis with the IBM SPSS Statistics 26 application. The data obtained (pH and viscosity) was tested for normality and was analyzed using One Way ANOVA with α of 5%, and then proceed with the Tukey test. The data analysis for stability test (storage temperature, before and after centrifugation and heating-cooling cycle test) was performed with paired T-test.
Physical evaluation
Based on the physical investigation, all of the nanoemulsion texture were semisolid, clear, and no separation. The color of nanoemulsion loaded extract was green and transparent. Meanwhile, the sample without extract was transparent and had a pale yellow colour. The type of nanoemulsion produced was oil in water (O/W) since methylene blue was evenly dispersed. The results showed that all the formula showed a homogeny dosage form. The pH determination ranged from 5.66±0.01 to 5.95±0.02 for nanoemulsion containing extract, while the blank formulation was 6.96±0.01. The addition of extract to the sample decreased the pH along with its concentration. The pH obtained in this result was still in line with the standard values for topical product, which is 4-6 [34]. The pH values recorded for the nanoemulsion were also in the safety range for the topical dosage form and was in the normal pH range of the skin.
The viscosity of nanoemulsion is one of its important characteristics, which also has an influence on the stability. The viscosity obtained from the formula in this study were ranged between 121.33±0.29 to 211.01±1.00 cps. The addition of the extract contributed to the viscosity enhancement of nanoemulsion. The higher the extract concentration, the higher the viscosity value obtained for the product. However, the statistical analysis showed that F3 and F4 were not significant different (p>0.05) in the pH and viscosity value. It demonstrated that the addition of the extract in the formula did not give a linear result to the pH neither the viscosity. The pH and the viscosity of the nanoemulsion are presented in table 2.
Table 2: The pH and viscosity value of clove oil nanoemulsion
| Formula | pH | Viscosity (cps) |
| F0 | 6.96±0.01* | 121.33±0.29* |
| F1 | 5.95±0.02* | 161.97±0.95* |
| F2 | 5.90±0.01* | 176.17±5.11* |
| F3 | 5.68±0.01 | 204.83±0.29 |
| F4 | 5.66±0.01 | 211.01±1.00 |
*Showed p<0.05, all values are expressed as mean±SD (n=3)
Particle size determination
The particle size determination of the clove oil nanoemulsion loaded with CRE was carried out to evaluate the effect of various CRE to the particle size distribution. Table 3 shows that all the formula produced nanoemulsion with particle size below than 300 nm. The blank formula gave a product with a size below than 200 nm and showed a very good PDI which was small than 0.07. The increasing extract concentration had minimal effect on the size of the nanoemulsion. Although, F1 had bigger particle size than F2, F3 and F4, its PDI was smaller compared to others. Polydispersity indicates the uniformity of droplet size within the formulation [35]. The small PDI value indicated a homogeneity size of the nanoemulsion [36].
Table 3: The particle size and zeta potential value of clove oil nanoemulsion
| Formula | Particle size (nm) | PDI | Zeta Potential (mV) |
| F0 | 171.6±3.05 | 0.063±0.01 | -0.2±0.06 |
| F1 | 255.3±2.35 | 0.138±0.01 | -14.3±0.35 |
| F2 | 218.8±3.30 | 0.278±0.01 | -11.1±0.25 |
| F3 | 230.4±3.37 | 0.280±0.01 | -11.3±0.35 |
| F4 | 224.6±0.70 | 0.236±0.01 | -10.7±0.20 |
All values are expressed as mean±SD (n=3)
The PDI value is a very important parameter that can influence the stability of the nanoemulsion. A small value of<0.3 indicated the monodisperse population of particle size in the formula, which is expected to increase the stability of the product [37, 38]. A high PDI value showed that the range of the particle size was very big and it decreased the stability of the nanoemulsion [39]. The distribution of the particle size of the product is presented in fig. 1 (1a, 1b, 1c and 1d). The results showed that the extract of c. roseus had an effect on the particle size distribution. The extract composition also influences the dispersion of the droplets in nanoemulsion.
The zeta potential value of the nanoemulsion ranged from-10.7 to-14.3 mV for all formulation containing the extract, while a value of-0.2 mV was obtained for the blank formula. Furthermore, the value has an effect on the stability of the product, and it is often determined by the surfactant component of the ingredients. The zeta potential value have a significant role in showing the stability profile of a nanoemulsion. A low value indicates the lack of stability as well as the tendency for aggregation or flocculation [40]. The zeta potential depends on the type of surfactant used and shows the surface charge of nanoemulsion droplet [41].
Storage stability studies
The CRE nanoemulsion dosage form showed a great stability on organoleptic, pH and viscosity profile after kept in room temperature (25±2 °C) for 3 mo. The texture of the nanoemulsion was semisolid, homogeny and transparent with no separation occurred. There were no significant changes on pH and viscosity of all formulation after the test was conducted (p>0.05). The data can be seen in table 4.
Heating-cooling cycle and centrifugation tests
The heating-cooling test was carried out to predict the stability of nanoemulsion in extreme storage condition. The nanoemulsion was in a good condition the results showed that there was no change in texture, color, pH, and viscosity of the nanoemulsion after it was kept at extreme temperature of 6 heating and cooling cycles (the change of pH and viscosity was not significant, p>0.05). The same results were also obtained after the centrifugation process for pH and viscosity of all formula. There was no significant change after the test (p>0.05).
The pH and viscosity of nanoemulsion after centrifugation and heating-cooling test are presented in fig. 2 and fig. 3.
Table 4: The pH and viscosity of nanoemulsion after 3 mo in room temperature
| Formula | pH | Viscosity (cps) | ||
| After preparation | After 3 mo | After preparation | After 3 mo | |
| F0 | 6.96±0.01 | 6.95±0.02 | 121.33±0.29 | 120±1.00 |
| F1 | 5.95±0.02 | 5.95±0.01 | 161.97±0.95 | 162.3±2.52 |
| F2 | 5.90±0.01 | 5.88±0.02 | 176.17±5.11 | 176.0±2.00 |
| F3 | 5.68±0.01 | 5.68±0,02 | 204.83±0.29 | 202.3±2.08 |
| F4 | 5.66±0.01 | 5.65±0.01 | 211.01±1.00 | 212.3±2.52 |
All values are expressed as mean±SD (n=3)

A

B

C

D

E
Fig. 1: Particle size distribution of the c. roseus nanoemulsion F1 (a), F2 (b), F3 (c), F4 (d), F5 (e)

Fig. 2: The pH of nanoemulsion after centrifugation and heating-cooling cycle test

Fig. 3: The influence of centrifugation and heating-cooling cycle test to viscosity of nanoemulsion
Antioxidant activity
The antioxidant effect of the preparation formulas was determined using the DPPH method by UV-Vis spectrophotometer at a wavelength of 516 nm. Measurement of IC50 value was carried out on the nanoemulsion formulation at various concentrations of extract. Furthermore, clove oil nanoemulsion preparations were also measured as blanks. The test results showed that the preparations had a moderate antioxidant effect because they were in the range of 100-150 µg/ml [42]. The IC50 value decreased along with the addition of extract, indicating an increase in the effectiveness of the products. The lower IC50 value showed better antioxidant activity. The IC50 decreased as more extract was added due to its contents with antioxidant activity, such as flavonoid [32]. The values obtained for the nanoemulsion preparation are presented in table 5.
Antibacterial activity
The results of the antibacterial activity testing are presented in table 6 and fig. 4. All the formula exhibited toxic effect against P. acnes and S. epidermidis. Furthermore, the nanoemulsion tested contained extract with concentrations of 0.5, 1, 1.5, and 2%. The blank zone around the disc indicated the nonexistence of bacterial growth. The wider the zone formed, the better the anti-bacterial effect. The inhibition zones of<12 mm was categorized as weak, 12-20 mm showed moderate activity, and>20 mm was classified strong category as antibacterial [43]. Therefore, the clove oil nanoemulsion loaded with CRE showed weak antibacterial activity against p. acnes, while it had a moderate effect on s. epidermidis.
Table 5: The antioxidant activity of nanoemulsion
| Formula | IC50 (ppm) |
| F0 | 124.30±4.32 |
| F1 | 112.78±3.37 |
| F2 | 108.08±3.36 |
| F3 | 102.27±2.85 |
| F4 | 96.29±3.64 |
| Vit C | 3.24±0.06 |
All values are expressed as mean±SD (n=3)
Table 6: Zone of inhibition of nanoemulsion
| Formula | Zone of inhibition (mm) | |
| P. acnes | S. epidermidis | |
| F0 (without clove oil) | 0 | 0 |
| F0 (with clove oil) | 9.10±0.90 | 8.77±0.75 |
| F1 | 9.35±0.85 | 12.97±0.45 |
| F2 | 9.47±2.05 | 13.03±1.25 |
| F3 | 10.15±0.65 | 13.20±0.20 |
| F4 | 10.65±0.15 | 13.27±0.21 |
All values are expressed as mean±SD (n=3)
Fig. 4: Zone of inhibition all nanoemulsion after 24 h P. acnes (a) and S. epidermidis (b)
In this study, the F0 samples used for antibacterial testing was divided into 2 groups, namely nanoemulsion preparation without clove oil and extract as well as preparation with clove oil as oil phase. This formula was a correction and comparative for the nanoemulsion. The blank formula still contains a preservative, such as methyl and propyl parabens, which was suspected to have antibacterial activity. The result showed that the blank group had no effect on the two evaluated bacteria, while the nanoemulsion using clove oil have effect on the bacteria. This finding indicated that clove oil showed antibacterial activity in the product, but the activity was very low at that concentration. Additionally, the administration of C. roseus extract exhibited and increasing antibacterial activity to the P. acnes and S. epidermidis and F4 showed the best antibacterial effect compared the other formula.
In this study, the CRE nanoemulsion using clove oil as oil phase was successfully produced with spontaneous emulsification method. It showed good physical characteristics and stability for 3 mo of storage. The variation of CRE concentration in nanoemulsion affects the pH, viscosity, antioxidant activity and antibacterial property of the product. The addition of CRE concentration decreases the pH and increases the viscocity of the nanoemulsion. The CRE nanoemulsions have antioxidant activity, which is classified in the moderate category and demonstrate antibacterial activity against p. acnes and s. epidermidis which depend on the concentration used.
This study was funded by the Universitas Sumatera Utara with the Grant number 54/UN5.3.2.1/PPM/SPP-TALENTA USU/2021.
All authors contributed equally.
Declared none
Chaieb K, Hajlaoui H, Zmantar T, Kahla Nakbi AB, Rouabhia M, Mahdouani K. The chemical composition and biological activity of clove essential oil, Eugenia caryophyllata (Syzigium aromaticum L. Myrtaceae): a short review. Phytother Res. 2007;21(6):501-6. doi: 10.1002/ptr.2124, PMID 17380552.
Kammon A. In vitro antimicrobial activity of clove oil against gram negative bacteria isolated from chickens. APDV 2019;6(2). doi: 10.31031/APDV.2019.06.000635.
Yadav AK, Ambasta SK, Prasad SK, Trivedi MP. In vitro evaluation of antibacterial property of catharanthus roseus (linn.) g. don. var. “rosea” and “alba”. Int J Pharm Pharm Sci. 2018;10(5):55-8. doi: 10.22159/ijpps.2018v10i5.24977, doi: 10.22159/ijpps.2018v10i5.24977.
Ginting EV, Retnaningrum E, Widiasih DA. Antibacterial activity of clove (Syzygium aromaticum) and cinnamon (Cinnamomum burmannii) essential oil against extended-spectrum β-lactamase-producing bacteria. Vet World. 2021;14(8):2206-11. doi: 10.14202/vetworld.2021.2206-2211. PMID 34566340.
Han X, Parker TL. Anti-inflammatory activity of clove (Eugenia caryophyllata) essential oil in human dermal fibroblasts. Pharm Biol. 2017;55(1):1619-22. doi: 10.1080/ 13880209.2017.1314513, PMID 28407719.
Hosseini M, Shahedi AM, Rakhshandeh H. Analgesic effect of clove essential oil in mice. Avicenna J Phytomed. 2011;1:1-6. doi: 10.22038/AJP.2011.114.
Gulcin I, Elmastas M, Aboul Enein HY. Antioxidant activity of clove oil–a powerful antioxidant source. Arab J Chem. 2012;5(4):489-99. doi: 10.1016/j.arabjc.2010.09.016.
Shahavi MH, Hosseini M, Jahanshahi M, Meyer RL, Darzi GN. Clove oil nanoemulsion as an effective antibacterial agent: Taguchi optimization method. Desalin Water Treat. 2016;57(39):18379-90. doi: 10.1080/19443994.2015.1092893.
Sun H, Luo D, Zheng S, Li Z, Xu W. Antimicrobial behavior and mechanism of clove oil nanoemulsion. J Food Sci Technol. 2022;59(5):1939-47. doi: 10.1007/s13197-021-05208-z, PMID 35531406.
Majeed A, Bashir R, Farooq S, Maqbool M. Preparation, characterization and applications of nanoemulsions: an insight. J Drug Delivery Ther 2019;9(2):520-7. doi: 10.22270/jddt.v9i2.2410.
Solans C, Izquierdo P, Nolla J, Azemar N, Garcia Celma MJ. Nano-emulsions. Curr Opin Colloid Interface Sci. 2005;10(3-4):102-10. doi: 10.1016/j.cocis.2005.06.004.
Aswathanarayan JB, Vittal RR. Nanoemulsions and their potential applications in food industry. Front Sustain Food Syst. 2019;3:95. doi: 10.3389/fsufs.2019.00095.
Maha HL, Sinaga KR, Sinaga KR, Masfria M, Masfria M. Formulation and evaluation of miconazole nitrate nanoemulsion and cream. Asian J Pharm Clin Res 2018;11(3). doi: 10.22159/ajpcr.2018.v11i3.22056.
Tayeb HH, Sainsbury F. Nanoemulsions in drug delivery: formulation to medical application. Nanomedicine (Lond). 2018;13(19):2507-25. doi: 10.2217/nnm-2018-0088, PMID 30265218.
Lonappan D, Krishnakumar K, Dineshkumar B. Nanoemulsion in pharmaceuticals. AJPTR. 2018;8(2):1-14. doi: 10.46624/ajptr.2018.v8.i2.001.
Che Marzuki NH, Wahab RA, Abdul Hamid M. An overview of nanoemulsion: concepts of development and cosmeceutical applications. Biotechnol Biotechnol Equip. 2019;33(1):779-97. doi: 10.1080/13102818.2019.1620124.
Sutradhar KB, Amin ML. Nanoemulsions: increasing possibilities in drug delivery. Eur J Nanomed. 2013;5(2):97-110. doi: 10.1515/ejnm-2013-0001.
Savardekar P, Bajaj A. Nanoemulsion-a review. Int J Res Pharm Chem. 2016;6(2):312-22.
Liu C, Jin H, Yu Y, Sun J, Zheng H, Zhang Y. The improvement of nanoemulsion stability and antioxidation via protein-chlorogenic acid-dextran conjugates as emulsifiers. Nanomaterials (Basel). 2020;10(6):1094. doi: 10.3390/nano10061094, PMID 32492859.
Prasetyo BE, Karsono SM, Maruhawa SM, Laila L. Formulation and physical evaluation of castor oil based nanoemulsion for diclofenac sodium delivery system. Res J Pharm Technol. 2018;11(9):3861-5. doi: 10.5958/0974-360X.2018.00707.2.
Prasetyo BE, Azmi N, Shamsuddin AF. Preparation and physical stability evaluation of palm oil-based nanoemulsion as a drug delivery system for propofol. JSKM. 2018;16(2):5-13. doi: 10.17576/jskm-2018-1602-02.
Ferreira LM, Cervi VF, Gehrcke M, da Silveira EF, Azambuja JH, Braganhol E. Ketoprofen-loaded pomegranate seed oil nanoemulsion stabilized by pullulan: selective antiglioma formulation for intravenous administration. Colloids Surf B Biointerfaces. 2015;130:272-7. doi: 10.1016/j.colsurfb.2015.04.023. PMID 25935266.
Tiong SH, Looi CY, Hazni H, Arya A, Paydar M, Wong WF. Antidiabetic and antioxidant properties of alkaloids from catharanthus roseus (L.) G. Don Molecules. 2013;18(8):9770-84. doi: 10.3390/molecules18089770, PMID 23955322.
Jaleel CA, Gopi R, Manivannan P, Panneerselvam R. Responses of antioxidant defense system of catharanthus roseus (L.) g. don to paclobutrazol treatment under salinity. Acta Physiol Plant. 2007;29(3):205-9. doi: 10.1007/s11738-007-0025-6.
Raza ML, Nasir M, Abbas T, Naqvi BS. Antibacterial activity of different extracts from the Catharanthus roseus. Clin Exp Med J. 2009;3(1):81-5. doi: 10.1556/CEMED.3.2009.1.7.
Hassan A. In vivo antidiarrheal activity of the ethanolic leaf extract of catharanthus roseus linn. (Apocyanaceae) in wistar rats. Afr J Pharm Pharmacol. 2011;5(15):1797-800. doi: 10.5897/AJPP11.505.
Mariadi, Prasetyo BE, Adela H, Wiladatika W. Formulation and characterization of nanoemulsion of tread leave ethanol extract (Catharanthus roseus (L.) G. Don) as antihyperglycemic. IDJPCR 2019;2(2):24-30. doi: 10.32734/idjpcr.v2i2.3204.
Nisar A, Mamat AS, Hatim MI, Aslam MS, Syarhabil M. An updated review on catharanthus roseus: phytochemical and pharmacological analysis. Indian Res J Pharm Sci. 2016;3(2):631-53.
Suciati T, Aliyandi A, Satrialdi. Development of transdermal nanoemulsion formulation for simultaneous delivery of protein vaccine and artin-m adjuvant. Int J Pharm Pharm Sci. 2014;6(6):536-46.
Iradhati AH, Jufri M. Formulation and physical stability test of griseofulvin microemulsion gel. Int J App Pharm. 2017;9:23-6. doi: 10.22159/ijap.2017.v9s1.22_27.
Qorina F, Arsianti A, Fithrotunnisa Q, Tejaputri NA. Phytochemistry and antioxidant activity of soursop (Annona muricata) leaves. Int J Appl Pharm. 2019;11Special Issue 6:1-6. doi: 10.22159/ijap.2019.v11s6.33524.
Banne Y, Ponidjan TS, Dumanauw JM. Antioxidant and hepatoprotective activity of abelmoschus manihot l. medik leaf fraction against CCL4-induced liver damage in rats. Int J App Pharm. 2019;M1009:17-9. doi: 10.22159/ijap.2019.v11s3.M1009.
Ardhany SD, Novaryatiin S. Antibacterial activity of ethanolic extract bawang dayak (Eleutherine bulbosa (Mill.) Urb) in cream against propionibacterium acnes. Int J App Pharm. 2019;T0020:1-4. doi: 10.22159/ijap.2019.v11s5.T0020.
Lukic M, Pantelic I, Savic SD. Towards optimal ph of the skin and topical formulations: from the current state of the art to tailored products. Cosmetics. 2021;8(3):69. doi: 10.3390/cosmetics8030069.
Amin N, Das B. A review on formulation and characterization of nanoemulsion. Int J Curr Pharm Sci. 2019:1-5. doi: 10.22159/ijcpr.2019v11i4.34925. doi: 10.22159/ijcpr.2019v11i4.34925.
Badran M. Formulation and in vitro evaluation of flufenamic acid loaded deformable liposomes for improved skin delivery. Dig J Nanomater Biostructures. 2014;9(1):83-91.
Danaei M, Dehghankhold M, Ataei S, Hasanzadeh Davarani F, Javanmard R, Dokhani A. Impact of particle size and polydispersity index on the clinical applications of lipidic nanocarrier systems. Pharmaceutics. 2018;10(2):57. doi: 10.3390/pharmaceutics10020057, PMID 29783687.
Shehzad Q, Rehman A, Ali A, Khan S, Mahdi AA, Karim A. Preparation and characterization of resveratrol loaded nanoemulsions. Int J Agric Innov Res. 2020;8:300-10.
Suryani HNHA, Halid NHA, Akib NI, Rahmanpiu, Mutmainnah N. Preparation of curcumin nanoparticle by using reinforcement ionic gelation technique. AIP Conf Proc. 2016;1838:020013. doi: 10.1063/1.4982185.
Ahmadi O, Jafarizadeh Malmiri HJ. Intensification process in thyme essential oil nanoemulsion preparation based on subcritical water as green solvent and six different emulsifiers. Green Process Synth. 2021;10(1):430-9. doi: 10.1515/gps-2021-0040.
Winarti L. Formulation of self-nanoemulsifying drug delivery system of bovine serum albumin using hlb (hydrophilic-lypophilic balance) approach. Indonesian J Pharm 2016;27(3):117-27. doi: 10.14499/indonesianjpharm27iss3pp117.
Yuniarti R, Nadia S, Alamanda A, Zubir M, Syahputra RA, Nizam M. Characterization, phytochemical screenings and antioxidant activity test of kratom leaf ethanol extract (Mitragyna speciosa korth) using DPPH method. J Phys: Conf Ser. 2020;1462(1). doi: 10.1088/1742-6596/1462/1/012026.
Shahbazi Y. Antibacterial and antioxidant properties of methanolic extracts of apple (Malus pumila), grape (Vitis vinifera), pomegranate (Punica granatum L.) and common fig (Ficus carica L.) fruits. Pharm Sci. 2017;23(4):308-15. doi: 10.15171/PS.2017.45.